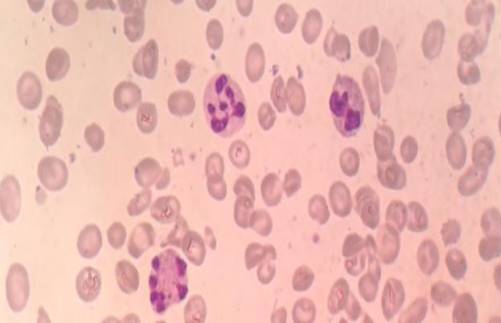

Pengaruh Penyimpanan Darah pada Pemeriksaan Darah Lengkap
Terkadang spesimen darah yang dikirim ke laboratorium tidak segera dilakukan pemeriksaan, terutama pada laboratorium yang memiliki jumlah pasien sangat banyak. Antrian yang banyak saat melakukan “billing”, memasukkan data identitas spesimen, saat akan memasukkan ke alat, atau adanya tambahan pemeriksaan, dimana spesimen berada pada suhu ruang dalam jangka waktu yang lama.
Berbeda dengan spesimen serum, spesimen darah dengan antikoagulan EDTA yang digunakan untuk pemeriksaan darah lengkap (DL) dapat segera mengalami berbagai perubahan jika dibiarkan pada suhu ruang, dan perubahan terjadi lebih cepat pada suhu ruang yang lebih tinggi.
Berikut beberapa perubahan yang dapat terjadi pada penyimpanan spesimen DL pada suhu ruang:
- 2 jam setelah pengambilan darah: hitung leukosit (terutama limfosit) dan trombosit mulai turun
- 6 jam setelah pengambilan darah: hitung retikulosit mulai turun
- 8 jam setelah pengambilan darah: jumlah eritrosit, leukosit, trombosit, dan indeks eritrosit masih stabil; hematokrit dan MCV mulai meningkat; fragilitas osmotik meningkat; LED turun
- 1-3 hari: normoblast menghilang, kadar Hb stabil, eritrosit mulai lisis
Perubahan tidak hanya terjadi pada jumlah, tapi juga pada morfologi sel pada apusan darah. Perubahan morfologi mulai terlihat 3 jam setelah pengambilan darah, dan semakin jelas setelah 12-18 jam. Berikut beberapa perubahan morfologi yang dapat ditemukan:
- netrofil: warna inti menjadi homogen, lobus segmen makin terpisah, batas sitoplasma kurang jelas, dan muncul vakuol di sitoplasma.
- monosit: vakuol di sitoplasma dan inti mulai pecah.
- limfosit: vakuol di sitoplasma, warna inti jadi lebih homogen, dan inti “budding” (kesan 2-3 lobus inti)
- eritrosit (terlihat >6 jam): krenasi dan membulat seperti sferosit

Penyimpanan spesimen DL pada suhu 4oC (dalam lemari es) dalam waktu 24 jam tidak memiliki pengaruh yang signifikan pada hitung sel darah, termasuk hitung retikulosit. Walau spesimen DL dapat disimpan dalam lemari es dalam semalam, sebaiknya pemeriksaan DL segera dikerjakan sesaat setelah pengambilan darah. Begitu juga untuk apusan darah tepi, masih bisa terjadi perubahan morfologi sel pada spesimen yang disimpan pada suhu 4oC walaupun dalam waktu yang lebih lama dibanding suhu ruang. Hal ini menunjukkan pentingnya membuat apusan segera setelah pengambilan darah, dengan batas waktu kurang dari 3 jam.
Semoga bermanfaat.
Referensi: Dacie and Lewis Practical Haematology.